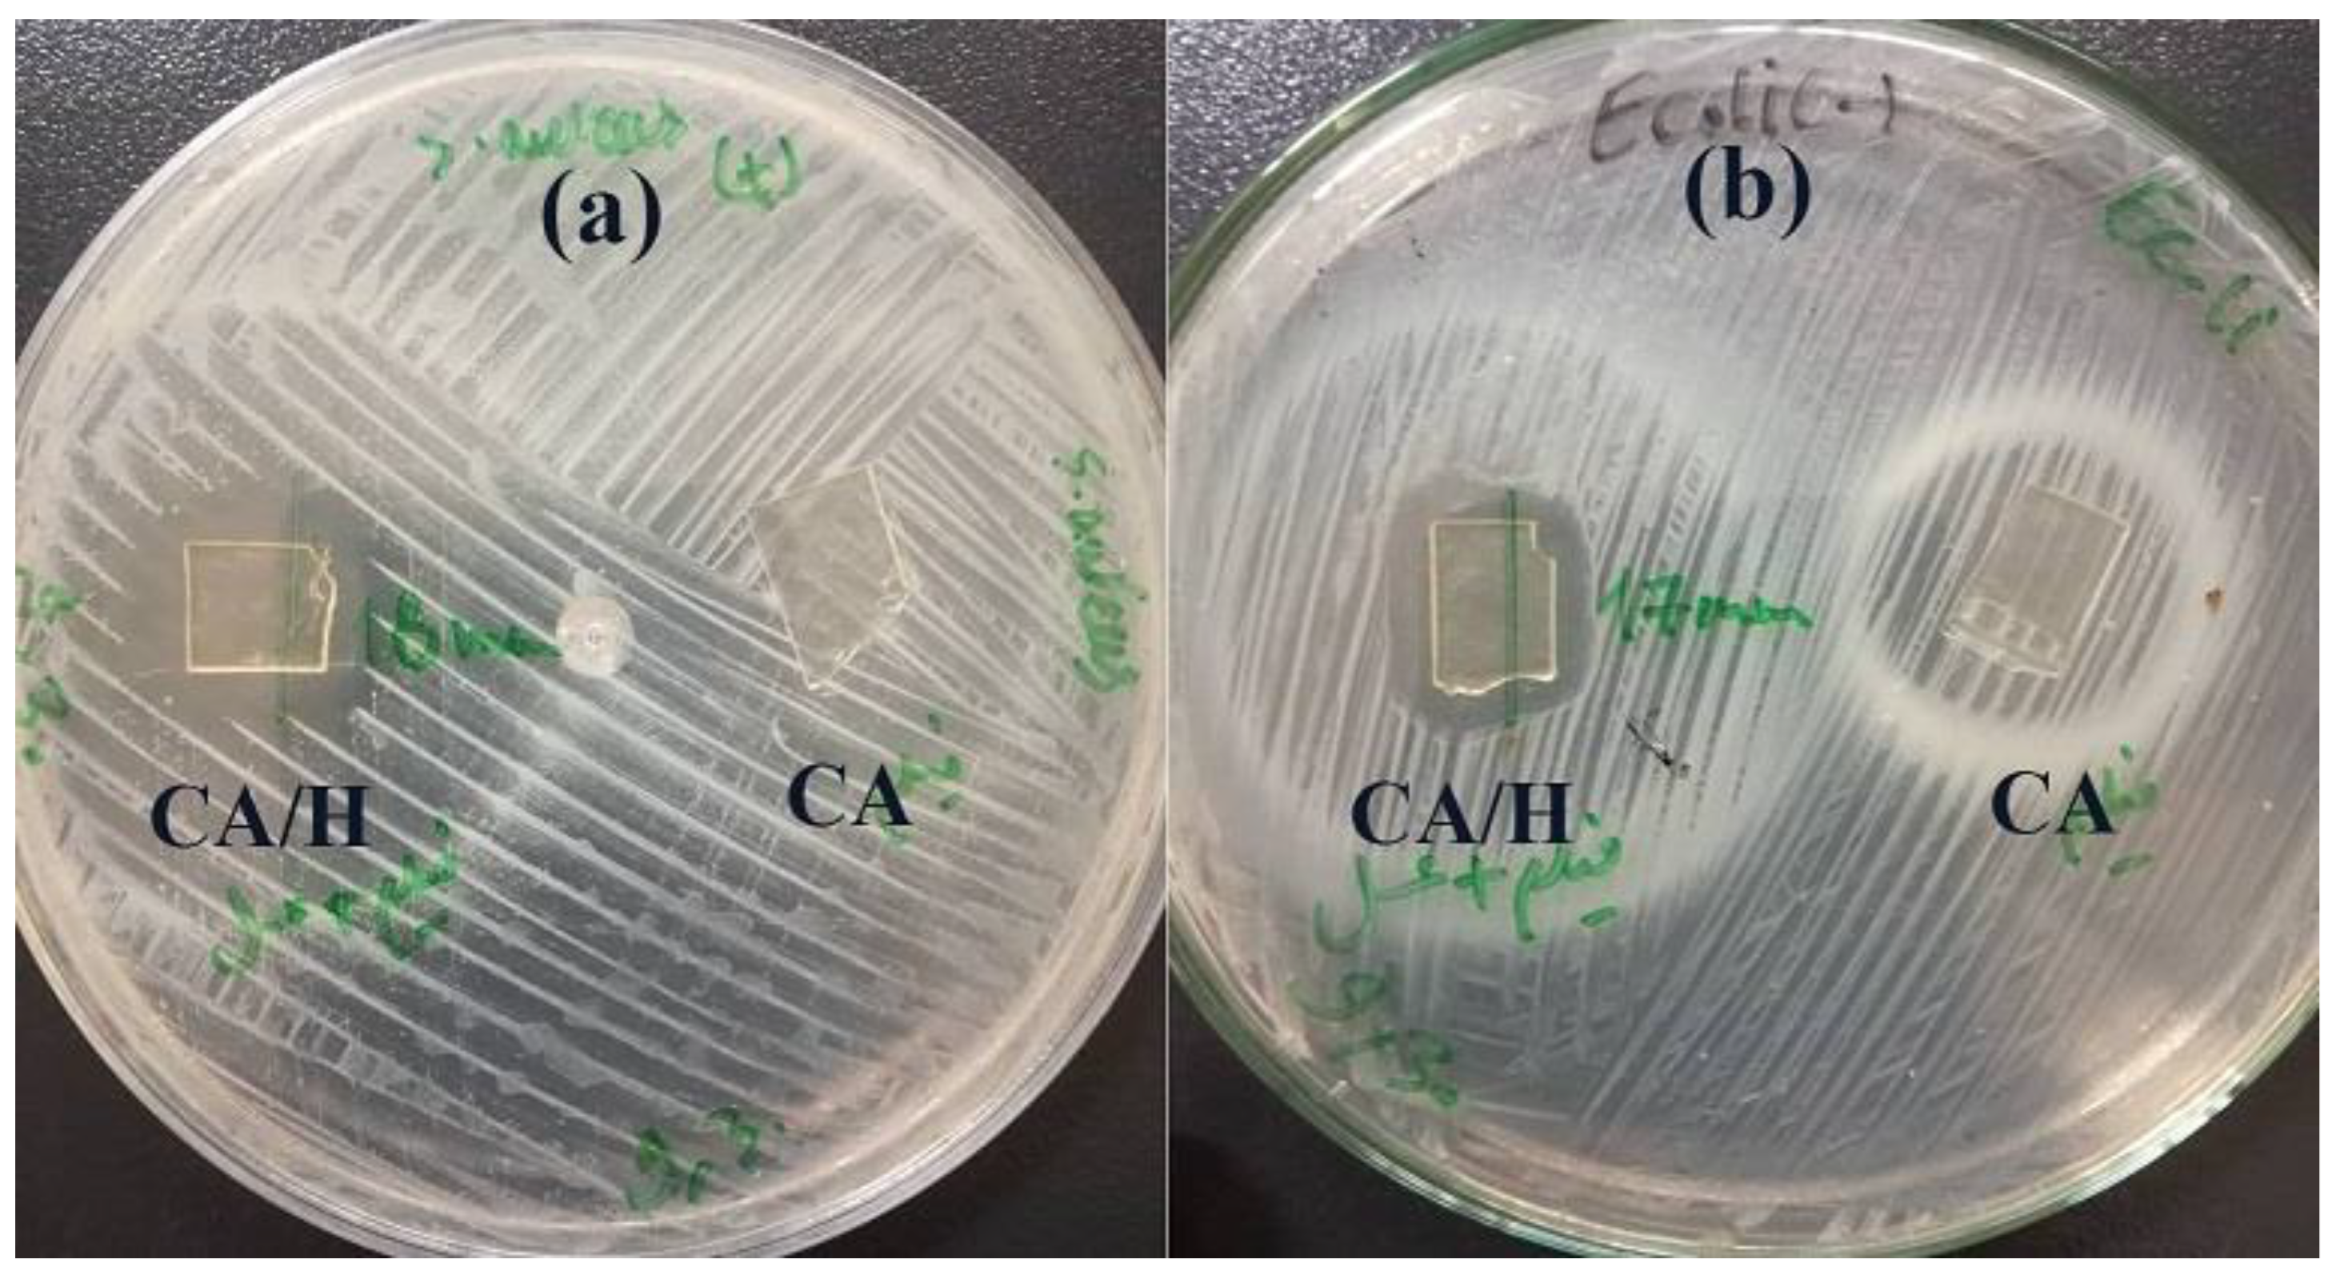
Jfb 14 00072 g005

Anthocyanin/Honey-Incorporated Alginate Hydrogel as a Bio-Based pH-Responsive/Antibacterial/Antioxidant Wound Dressing
Abstract
1. Introduction
2. Materials and Methods
2.1. Materials
2.2. Extractions of Red Cabbage Anthocyanins
2.3. Preparation of Sodium Alginate Hydrogel Films
2.4. Characterization of the Hydrogel Films
2.4.1. Mechanical Properties
2.4.2. Water Uptake
2.4.3. Water Retention
2.5. Fourier Transform Infrared Spectroscopy (FTIR)
2.6. Antioxidant Activity Assay
2.7. Antibacterial Study
2.8. pH-Sensitive Color Change
2.9. Cell Viability Assay
2.10. Statistical Analysis
3. Results and Discussion
3.1. Characterization of Hydrogel Film Samples
3.2. FTIR Study
3.3. Antibacterial Properties of the Hydrogel Film
3.4. Antioxidant Activity
3.5. pH-Responsive Color Change
3.6. Cell Viability
4. Conclusions
Author Contributions
Funding
Institutional Review Board Statement
Informed Consent Statement
Data Availability Statement
Conflicts of Interest
References
- Ojeh, N.; Pastar, I.; Tomic-Canic, M.; Stojadinovic, O. Stem cells in skin regeneration, wound healing, and their clinical applications. Int. J. Mol. Sci. 2015, 16, 25476–25501. [Google Scholar] [CrossRef] [PubMed]
- Meamar, R.; Ghasemi-Mobarakeh, L.; Norouzi, M.-R.; Siavash, M.; Hamblin, M.R.; Fesharaki, M. Improved wound healing of diabetic foot ulcers using human placenta-derived mesenchymal stem cells in gelatin electrospun nanofibrous scaffolds plus a platelet-rich plasma gel: A randomized clinical trial. Int. Immunopharmacol. 2021, 101, 108282. [Google Scholar] [CrossRef] [PubMed]
- Velnar, T.; Bailey, T.; Smrkolj, V. The wound healing process: An overview of the cellular and molecular mechanisms. Int. J. Med. Res. 2009, 37, 1528–1542. [Google Scholar] [CrossRef] [PubMed]
- Simões, D.; Miguel, S.P.; Ribeiro, M.P.; Coutinho, P.; Mendonça, A.G.; Correia, I.J. Recent advances on antimicrobial wound dressing: A review. Eur. J. Pharm. Biopharm. 2018, 127, 130–141. [Google Scholar] [CrossRef]
- Homaeigohar, S.; Boccaccini, A.R. Antibacterial biohybrid nanofibers for wound dressings. Acta Biomater. 2020, 107, 25–49. [Google Scholar] [CrossRef]
- Cordis. Available online: https://cordis.europa.eu/article/id/92892-device-for-diabetic-foot-ulcers (accessed on 2 April 2014).
- Norouzi, M.-R.; Ghasemi-Mobarakeh, L.; Gharibi, H.; Meamar, R.; Ajalloueian, F.; Chronakis, I.S. Surface modification of poly (ethylene terephthalate) fabric by soy protein isolate hydrogel for wound dressing application. Int. J. Polym. Mater. 2019, 68, 714–722. [Google Scholar] [CrossRef]
- Azimi, B.; Maleki, H.; Zavagna, L.; De la Ossa, J.G.; Linari, S.; Lazzeri, A.; Danti, S. Bio-based electrospun fibers for wound healing. J. Funct. Biomater. 2020, 11, 67. [Google Scholar] [CrossRef]
- Vishwakarma, A.; Bhise, N.S.; Evangelista, M.B.; Rouwkema, J.; Dokmeci, M.R.; Ghaemmaghami, A.M.; Vrana, N.E.; Khademhosseini, A. Engineering immunomodulatory biomaterials to tune the inflammatory response. Trends Biotechnol. 2016, 34, 470–482. [Google Scholar] [CrossRef]
- Molan, P.C. The evidence supporting the use of honey as a wound dressing. Int. J. Low. Extrem. Wounds 2006, 5, 40–54. [Google Scholar] [CrossRef]
- Meo, S.A.; Al-Asiri, S.A.; Mahesar, A.L.; Ansari, M.J. Role of honey in modern medicine. Saudi J. Biol. Sci. 2017, 24, 975–978. [Google Scholar] [CrossRef]
- Ingle, R.; Levin, J.; Polinder, K. Wound healing with honey-a randomised controlled trial. S. Afr. Med. J. 2006, 96, 831–835. [Google Scholar] [PubMed]
- Robson, V.; Dodd, S.; Thomas, S. Standardized antibacterial honey (Medihoney™) with standard therapy in wound care: Randomized clinical trial. J. Adv. Nurs. 2009, 65, 565–575. [Google Scholar] [CrossRef] [PubMed]
- Hazrati, M.; Mehrabani, D.; Japoni, A.; Montasery, H.; Azarpira, N.; Hamidian-Shirazi, A.; Tanideh, N. Effect of honey on healing of Pseudomonas aeruginosa infected burn wounds in rat. J. Appl. Anim. Res. 2010, 37, 161–165. [Google Scholar] [CrossRef]
- Lee, K.Y.; Mooney, D.J. Alginate: Properties and biomedical applications. Prog. Polym. Sci. 2012, 37, 106–126. [Google Scholar] [CrossRef] [PubMed]
- Norouzi, M.-R.; Ghasemi-Mobarakeh, L.; Itel, F.; Schoeller, J.; Fashandi, H.; Borzi, A.; Neels, A.; Fortunato, G.; Rossi, R.M. Emulsion electrospinning of sodium alginate/poly (ε-caprolactone) core/shell nanofibers for biomedical applications. Nanoscale Adv. 2022, 4, 2929–2941. [Google Scholar] [CrossRef]
- Varaprasad, K.; Jayaramudu, T.; Kanikireddy, V.; Toro, C.; Sadiku, E.R. Alginate-based composite materials for wound dressing application: A mini review. Carbohydr. Polym. 2020, 236, 116025. [Google Scholar] [CrossRef]
- Qin, Y. The gel swelling properties of alginate fibers and their applications in wound management. Polym. Adv. Technol. 2008, 19, 6–14. [Google Scholar] [CrossRef]
- Zhou, Q.; Kang, H.; Bielec, M.; Wu, X.; Cheng, Q.; Wei, W.; Dai, H. Influence of different divalent ions cross-linking sodium alginate-polyacrylamide hydrogels on antibacterial properties and wound healing. Carbohydr. Polym. 2018, 197, 292–304. [Google Scholar] [CrossRef]
- Russo, R.; Malinconico, M.; Santagata, G. Effect of cross-linking with calcium ions on the physical properties of alginate films. Biomacromolecules 2007, 8, 3193–3197. [Google Scholar] [CrossRef]
- Song, C.K.; Kim, M.-K.; Lee, J.; Davaa, E.; Baskaran, R.; Yang, S.-G. Dopa-empowered Schiff base forming alginate hydrogel glue for rapid hemostatic control. Macromol. Res. 2019, 27, 119–125. [Google Scholar] [CrossRef]
- Barnett, S.; Varley, S. The effects of calcium alginate on wound healing. Ann. R. Coll. Surg. 1987, 69, 153. [Google Scholar]
- Wiczkowski, W.; Szawara-Nowak, D.; Topolska, J. Red cabbage anthocyanins: Profile, isolation, identification, and antioxidant activity. Int. Food Res. J. 2013, 51, 303–309. [Google Scholar] [CrossRef]
- Zhang, Y.; Butelli, E.; Martin, C. Engineering anthocyanin biosynthesis in plants. Curr. Opin. Plant Biol. 2014, 19, 81–90. [Google Scholar] [CrossRef] [PubMed]
- Banach, M.; Wiloch, M.; Zawada, K.; Cyplik, W.; Kujawski, W. Evaluation of antioxidant and anti-inflammatory activity of anthocyanin-rich water-soluble aronia dry extracts. Molecules 2020, 25, 4055. [Google Scholar] [CrossRef]
- Xu, Z.; Han, S.; Gu, Z.; Wu, J. Advances and impact of antioxidant hydrogel in chronic wound healing. Adv. Healthc. Mater. 2020, 9, 1901502. [Google Scholar] [CrossRef]
- Miguel, M.G. Anthocyanins: Antioxidant and/or anti-inflammatory activities. J. Appl. Pharm. Sci. 2011, 1, 7–15. [Google Scholar]
- Mehmood, N.; Hariz, A.; Fitridge, R.; Voelcker, N.H. Applications of modern sensors and wireless technology in effective wound management. J. Biomed. Mater. Res. B Appl. 2014, 102, 885–895. [Google Scholar] [CrossRef]
- Mukherjee, R.; Tewary, S.; Routray, A. Diagnostic and prognostic utility of non-invasive multimodal imaging in chronic wound monitoring: A systematic review. J. Med. Syst. 2017, 41, 46. [Google Scholar] [CrossRef]
- Shamsabadi, A.S.; Tavanai, H.; Ranjbar, M.; Farnood, A.; Bazarganipour, M. Electrochemical non-enzymatic sensing of glucose by gold nanoparticles incorporated graphene nanofibers. Mater. Today Commun. 2020, 24, 100963. [Google Scholar] [CrossRef]
- Kang, S.M.; Cho, H.; Jeon, D.; Park, S.H.; Shin, D.-S.; Heo, C.Y. A matrix metalloproteinase sensing biosensor for the evaluation of chronic wounds. BioChip J. 2019, 13, 323–332. [Google Scholar] [CrossRef]
- Dargaville, T.R.; Farrugia, B.L.; Broadbent, J.A.; Pace, S.; Upton, Z.; Voelcker, N.H. Sensors and imaging for wound healing: A review. Biosens. Bioelectron. 2013, 41, 30–42. [Google Scholar] [CrossRef] [PubMed]
- Jankowska, D.; Bannwarth, M.; Schulenburg, C.; Faccio, G.; Maniura-Weber, K.; Rossi, R.; Scherer, L.; Richter, M.; Boesel, L. Simultaneous detection of pH value and glucose concentrations for wound monitoring applications. Biosens. Bioelectron. 2017, 87, 312–319. [Google Scholar] [CrossRef] [PubMed]
- Dissemond, J.; Witthoff, M.; Brauns, T.; Haberer, D.; Goos, M. pH values in chronic wounds. Evaluation during modern wound therapy. Der Hautarzt Z. Dermatol. Venerol. Verwandte Geb. 2003, 54, 959–965. [Google Scholar]
- Patras, A. Stability and colour evaluation of red cabbage waste hydroethanolic extract in presence of different food additives or ingredients. Food Chem. 2019, 275, 539–548. [Google Scholar] [CrossRef]
- Banerjee, S.; Saikia, J.P.; Kumar, A.; Konwar, B. Antioxidant activity and haemolysis prevention efficiency of polyaniline nanofibers. Nanotechnology 2009, 21, 045101. [Google Scholar] [CrossRef]
- Da Silva, M.A.; Bierhalz, A.C.K.; Kieckbusch, T.G. Alginate and pectin composite films crosslinked with Ca2+ ions: Effect of the plasticizer concentration. Carbohydr. Polym. 2009, 77, 736–742. [Google Scholar] [CrossRef]
- Rezvani Ghomi, E.; Khalili, S.; Nouri Khorasani, S.; Esmaeely Neisiany, R.; Ramakrishna, S. Wound dressings: Current advances and future directions. J. Appl. Polym. Sci. 2019, 136, 47738. [Google Scholar] [CrossRef]
- Thomas, D.; Nath, M.S.; Mathew, N.; Reshmy, R.; Philip, E.; Latha, M. Alginate film modified with aloevera gel and cellulose nanocrystals for wound dressing application: Preparation, characterization and in vitro evaluation. J. Drug Deliv. Sci. Technol. 2020, 59, 101894. [Google Scholar] [CrossRef]
- Abedi-Firoozjah, R.; Yousefi, S.; Heydari, M.; Seyedfatehi, F.; Jafarzadeh, S.; Mohammadi, R.; Rouhi, M.; Garavand, F. Application of red cabbage anthocyanins as pH-sensitive pigments in smart food packaging and sensors. Polymers 2022, 14, 1629. [Google Scholar] [CrossRef]
- Bertoncelj, J.; Polak, T.; Kropf, U.; Korošec, M.; Golob, T. LC-DAD-ESI/MS analysis of flavonoids and abscisic acid with chemometric approach for the classification of Slovenian honey. Food Chem. 2011, 127, 296–302. [Google Scholar] [CrossRef]
- Abou Zekry, S.S.; Abdellatif, A.; Azzazy, H.M. Fabrication of pomegranate/honey nanofibers for use as antibacterial wound dressings. Wound Med. 2020, 28, 100181. [Google Scholar] [CrossRef]
- Al-Waili, N.; Salom, K.; Al-Ghamdi, A.A. Honey for wound healing, ulcers, and burns; data supporting its use in clinical practice. Sci. World J. 2011, 11, 766–787. [Google Scholar] [CrossRef] [PubMed]
- El-Kased, R.F.; Amer, R.I.; Attia, D.; Elmazar, M.M. Honey-based hydrogel: In vitro and comparative In vivo evaluation for burn wound healing. Sci. Rep. 2017, 7, 9692. [Google Scholar] [CrossRef] [PubMed]
- Selvaraj, S.; Fathima, N.N. Fenugreek Incorporated Silk Fibroin Nanofibers A Potential Antioxidant Scaffold for Enhanced Wound Healing. ACS Appl. Mater. Interfaces 2017, 9, 5916–5926. [Google Scholar] [CrossRef]
- Fitzmaurice, S.; Sivamani, R.K.; Isseroff, R.R. Antioxidant therapies for wound healing: A clinical guide to currently commercially available products. Skin Pharmacol. Physiol. 2011, 24, 113–126. [Google Scholar] [CrossRef]
- Thangavel, P.; Ramachandran, B.; Kannan, R.; Muthuvijayan, V. Biomimetic hydrogel loaded with silk and l-proline for tissue engineering and wound healing applications. J. Biomed. Mater. Res. B Appl. 2017, 105, 1401–1408. [Google Scholar] [CrossRef]
- Qi, X.; Tong, X.; You, S.; Mao, R.; Cai, E.; Pan, W.; Zhang, C.; Hu, R.; Shen, J. Mild hyperthermia-assisted ROS scavenging hydrogels achieve diabetic wound healing. ACS Macro Lett. 2022, 11, 861–867. [Google Scholar] [CrossRef]
- Liang, T.; Sun, G.; Cao, L.; Li, J.; Wang, L. A pH and NH3 sensing intelligent film based on Artemisia sphaerocephala Krasch. gum and red cabbage anthocyanins anchored by carboxymethyl cellulose sodium added as a host complex. Food Hydrocoll. 2019, 87, 858–868. [Google Scholar] [CrossRef]
- AL-JADI, A.; ENCHANG, F.K.; Yusoff, K.M. The effect of Malaysian honey and its major components on the proliferation of cultured fibroblasts. Turk. J. Med. Sci. 2014, 44, 733–740. [Google Scholar] [CrossRef]
- Edgar, S.; Hopley, B.; Genovese, L.; Sibilla, S.; Laight, D.; Shute, J. Effects of collagen-derived bioactive peptides and natural antioxidant compounds on proliferation and matrix protein synthesis by cultured normal human dermal fibroblasts. Sci. Rep. 2018, 8, 10474. [Google Scholar] [CrossRef]

| Sample | Honey Loading | Elastic Modulus (MPa) | Tensile Strength (MPa) | Elongation at Break (%) |
|---|---|---|---|---|
| CA/H | 200% | 5.1 ± 0.63 | 3.22 ± 0.91 | 0.69 ± 0.17 |
| CA/H | 400% | 1.7 ± 0.54 | 6.15 ± 1.20 | 4.75 ± 1.26 |
| Sample | Inhibition Zone against S. aureus (mm) | Inhibition Zone against E. Coli (mm) |
|---|---|---|
| CA/H | 18 ± 2 | 17 ± 3 |
| CA/H/RCE | 19 ± 3 | 18 ± 4 |
Disclaimer/Publisher’s Note: The statements, opinions and data contained in all publications are solely those of the individual author(s) and contributor(s) and not of MDPI and/or the editor(s). MDPI and/or the editor(s) disclaim responsibility for any injury to people or property resulting from any ideas, methods, instructions or products referred to in the content. |
© 2023 by the authors. Licensee MDPI, Basel, Switzerland. This article is an open access article distributed under the terms and conditions of the Creative Commons Attribution (CC BY) license (https://creativecommons.org/licenses/by/4.0/).
Share and Cite
Lotfinia, F.; Norouzi, M.-R.; Ghasemi-Mobarakeh, L.; Naeimirad, M. Anthocyanin/Honey-Incorporated Alginate Hydrogel as a Bio-Based pH-Responsive/Antibacterial/Antioxidant Wound Dressing. J. Funct. Biomater. 2023, 14, 72. https://doi.org/10.3390/jfb14020072
Lotfinia F, Norouzi M-R, Ghasemi-Mobarakeh L, Naeimirad M. Anthocyanin/Honey-Incorporated Alginate Hydrogel as a Bio-Based pH-Responsive/Antibacterial/Antioxidant Wound Dressing. Journal of Functional Biomaterials. 2023; 14(2):72. https://doi.org/10.3390/jfb14020072
Chicago/Turabian StyleLotfinia, Faezeh, Mohammad-Reza Norouzi, Laleh Ghasemi-Mobarakeh, and Mohammadreza Naeimirad. 2023. "Anthocyanin/Honey-Incorporated Alginate Hydrogel as a Bio-Based pH-Responsive/Antibacterial/Antioxidant Wound Dressing" Journal of Functional Biomaterials 14, no. 2: 72. https://doi.org/10.3390/jfb14020072
APA StyleLotfinia, F., Norouzi, M.-R., Ghasemi-Mobarakeh, L., & Naeimirad, M. (2023). Anthocyanin/Honey-Incorporated Alginate Hydrogel as a Bio-Based pH-Responsive/Antibacterial/Antioxidant Wound Dressing. Journal of Functional Biomaterials, 14(2), 72. https://doi.org/10.3390/jfb14020072






